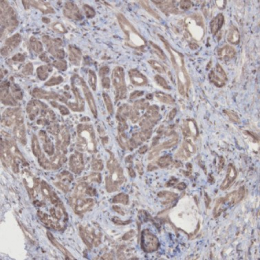
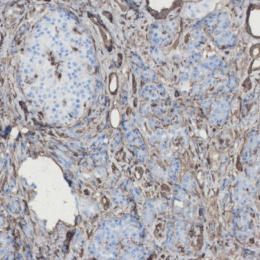
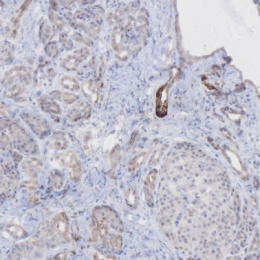
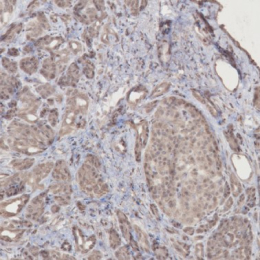

Price | 1784€+ Login to see price |
Organism | Human |
Product Type | Organoid |
Tissue | Pancreatic ducts, Pancreatic endocrine cells |
Disease | Pancreatic cancer |
Oncology
Small Molecule
Antibody
Cancer Vaccine
mRNA
Immune Cell
TME-CAF
Immuno Oncology
Macrophage
Regulatory T Cell
Tumor-Infiltrating Lymphocyte
Cytotoxic T Cell

“...However, predicting drug responsiveness has been challenging due to variability between patients. Lambda Biologics’ patient-derived organoids address this issue by reflecting the unique characteristics of individual patients. These organoids allow...

“...However, predicting drug responsiveness has been challenging due to variability between patients. Lambda Biologics’ patient-derived organoids address this issue by reflecting the unique characteristics of individual patients. These organoids allow...

“...However, predicting drug responsiveness has been challenging due to variability between patients. Lambda Biologics’ patient-derived organoids address this issue by reflecting the unique characteristics of individual patients. These organoids allow...
Step into the future of oncology with Lambda AF Solution’s Human Pancreatic Cancer Organoids. Crafted with cutting-edge 3D culture technology, these organoids bring the complex environment of pancreatic cancer right to your lab. Perfect for delving into tumor heterogeneity and enhancing drug testing—pioneering precision medicine starts here!


Pancreatic cancer organoid
H&E | ANXA1 | ANXA10 | ANXA13 | |
|---|---|---|---|---|
Cancer tissue |  |  |  | |
Cancer tissue |  | | | |
Cancer organoid |  |  |  |  |
Cancer organoid |  |  |  |  |
Unlock the essence of precision in cancer treatment with our PC organoids, mirroring the genetic markers of pancreatic cancer.
Experience the future of testing your drugs, serving as an invaluable tool in capturing the patient-specific characteristics, thereby providing a more accurate platform for studying tumor biology and testing.
Dive into a new era of oncology, where your individuality guides our innovation.
Performing WES analysis on 7pancreatic cancer (hPC) organoid samples, the top 25 gene mutations were observed to be noticeably present across the samples, indicating a high level of mutation.
According to these results, it appears that conducting experiments using the various types of pancreatic cancer samples we possess will likely yield results similar to those observed in actual human cases.

Using hPC Organoid, we statistically analyze the correlation between genetic mutations in proteins and protein-to-protein databases to confirm the associative relationships of genes

Embrace personalized medicine with our cutting-edge platform:
Test your drug’s effectiveness against conventional treatments under optimal conditions and discover tailored therapeutic responses. Transform the standard with us—where your medication’s potential is as unique as you are.

hPC Gemcitabine

hPC Paclitaxel
We have confirmed varying efficacy among patients when treating pancreatic cancer organoids derived from patients with representative chemotherapeutic agents such as gemcitabine and paclitaxel.
This underscores the potential for selecting personalized drugs tailored to each patient.
Furthermore, matching these treatments with patients genetic profiles could significantly aid in selecting appropriate chemotherapy agents. We aim to contribute to the advancement of personalized cancer therapy based on these findings.
Each patient displays individual variations in drug response patterns, making it possible to explore the optimal medication for each patient. Explore patient-specific drug reactivity using our state-of-the-art platform. Assess your medication’s efficacy compared to standard treatments in optimal conditions and uncover customized therapeutic responses.
Patient#1 G12D | Patient#2 G12V | Patient#3 G12D | Patient#4 G12V | |
|---|---|---|---|---|
Vehicle |  |  |  |  |
Drug X |  |  |  |  |
Dead cell
Nuclear